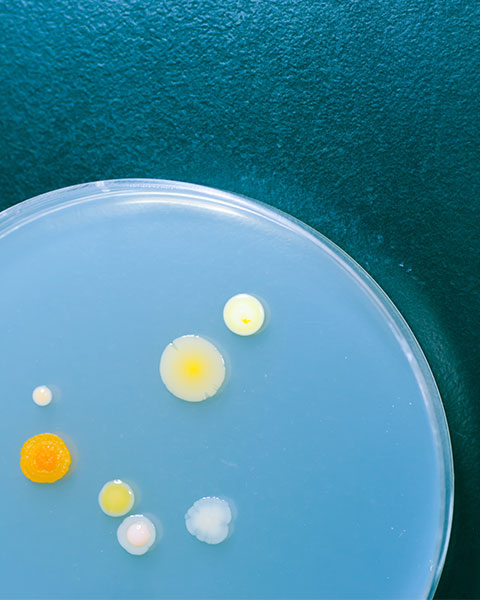

利用分析16S ribosomal
RNA的序列鑑定細菌的菌種。
16S rRNA為在細菌中組成ribosome的次單位,且突變率較低,與新物種產生速率相近。
細菌ribosomal operon結構:
真菌具多樣化型態,比對 DNA
序列為準確鑑定的必備工具。
利用分析真菌 ribosomal operon 的 internal transcribed
spacer(ITS)序列鑑定真菌的菌種。
真菌 ribosomal operon 結構:

| 藥物種類 | 原因 | 抗藥性的改變 |
|---|---|---|
| isoniazid | 抑制DNA-dependent RNA合成 | rpoB基因突變 |
| rifampicin | 抑制DNA-dependent RNA合成 | KatG 、inhA、 ahpC基因突變 |
